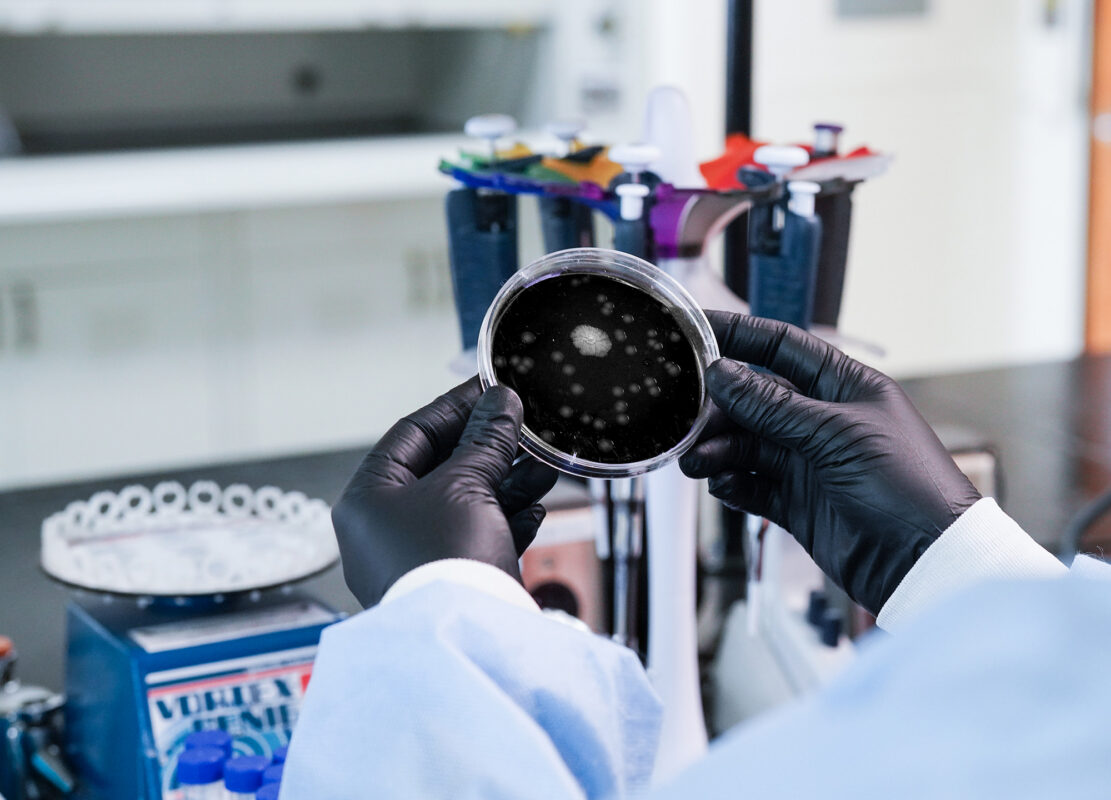
ISO Spread Plate test

Science for Purpose
We utilize state-of-the-art technologies to relentlessly improve our ability to capture, assess, and guide our clients to solve the challenges of water management.

OBJECTIVE WATER MANAGEMENT
Phigenics is an independent provider of Water Management Programs aligned with ANSI/ASHRAE 188 and Centers for Medicare & Medicaid Services (CMS) QSO 17-30.
We utilize state-of-the-art technologies to relentlessly improve our ability to capture, assess, and guide our clients to solve the challenges of water management.
We look at the whole picture to understand all the drivers of building water safety and how they work together.

We deploy a unique, integrated set of capabilities that provide an end-to-end solution from design to ongoing operations.

We give institutions confidence they are protecting those they serve from known risks related to building water systems.
